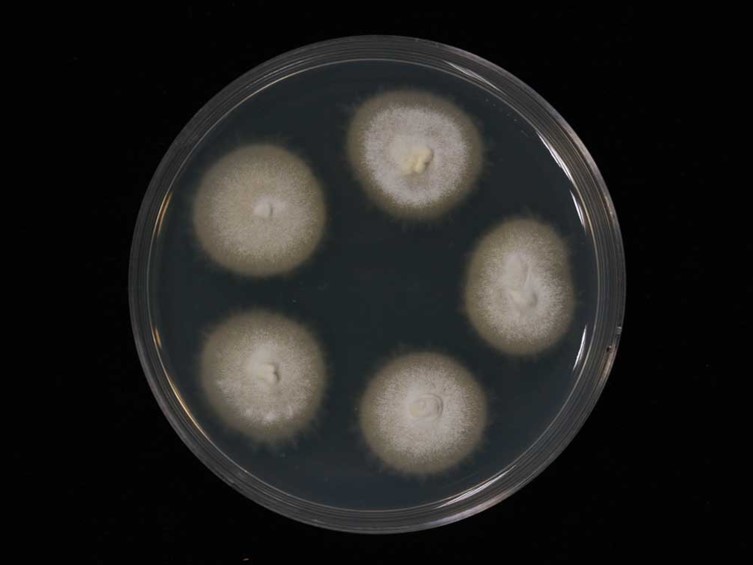

Holotype:
THAILAND, Loei Province, Chatchanat Farm, 26 Sep. 2006, K. Tasanathai, S. Mongkolsamrit, B. Thongnuch, R. Ridkaew, P. Srikitikulchai, C. Chuaseeharonnachai, holotype BBH 18836, ex-type living culture BCC 23107.
Habitat:
Leaf litters, buried in the soil.
Host:
Crickets.
Description:
 Stroma on body and leg joints of adult orthoptera, scattered, simple or branched, cylindrical to enlarged at the apices, yellowish cream, 1-3 mm long, with
Stroma on body and leg joints of adult orthoptera, scattered, simple or branched, cylindrical to enlarged at the apices, yellowish cream, 1-3 mm long, with  perithecia in small clusters (20-30) at the apices. Perithecia narrowly ovoid with acute apices, 650-710 × 280-320 μm, superficial and crowded at the apex.
perithecia in small clusters (20-30) at the apices. Perithecia narrowly ovoid with acute apices, 650-710 × 280-320 μm, superficial and crowded at the apex.  Asci cylindrical, 370-450 × 5 μm, ascus-caps 2.5 μm. Ascospores filiform, breaking into 32 part spores, 5-10 × 1 μm. Synnemata are scattered on the body and legs of the host, cream to yellowish brown, smooth-walled, 2-6 mm in length. Phialides round or flask-shaped, producing conidia sympodially on divergent denticles, in whorls of two or more or singly, scattered along the hypha. Conidia oblong-ellipsoid, some concave to one side and flattened or convex to the other, 2-4 × 1.2−1.5 μm, white.
Asci cylindrical, 370-450 × 5 μm, ascus-caps 2.5 μm. Ascospores filiform, breaking into 32 part spores, 5-10 × 1 μm. Synnemata are scattered on the body and legs of the host, cream to yellowish brown, smooth-walled, 2-6 mm in length. Phialides round or flask-shaped, producing conidia sympodially on divergent denticles, in whorls of two or more or singly, scattered along the hypha. Conidia oblong-ellipsoid, some concave to one side and flattened or convex to the other, 2-4 × 1.2−1.5 μm, white.
Culture characteristics:
Colonies on PDA are relatively fast growing, reaching 10 mm diam after 14 d at 25 °C, circular, dense, at first white and floccose, becoming cream to yellow cream in the center with age, conidiation starts as early as 12 h after inoculation.
Colonies on PDA are relatively fast growing, reaching 10 mm diam after 14 d at 25 °C, circular, dense, at first white and floccose, becoming cream to yellow cream in the center with age, conidiation starts as early as 12 h after inoculation.
Reference:
Ariyawansa HA, Hyde KD, Jayasiri SC, et al. (2015). Fungal diversity notes 111–252—taxonomic and phylogenetic contributions to fungal taxa. Fungal Diversity 75: 27–274.
DOI: https://doi.org/10.1007/s13225-015-0346-5Khonsanit A, Luangsa-ard JJ, Thanakitpipattana D, et al. (2020). Cryptic diversity of the genus Beauveria with a new species from Thailand. Mycological Progress 19: 291–315.
DOI: https://doi.org/10.1007/s11557-020-01557-9Species |
Strain |
Compound |
Pubchem CID |
Biological activity |
Reference |
|---|
|
Strain |
ITS | RPB1 | RPB2 | TEF1 |
|---|---|---|---|---|
| BCC 23104 | FJ459784 | - | - | FJ459792 |
| BCC 23107 | FJ459786 | MK632183 | MK632156 | FJ459794 |
| BCC 66202 | MN401621 | MN401545 | MN401601 | MN401447 |
| BCC 68419 | MK632041 | MK632179 | MK632153 | MK632069 |
| BCC 68420 | - | MK632180 | MK632154 | MK632070 |